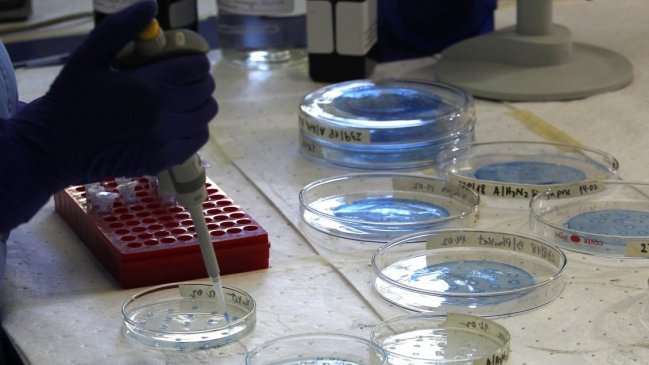
Detectan en Chile 22 casos de infección pulmonar por hongo tropical

El Instituto de Ciencias Biomédicas de la Facultad de Medicina de la Universidad de Chile (ICBM) ha detectado, desde 2017, 22 casos de infección pulmonar producto del histoplasma capsulatum, hongo proveniente de zonas de Sudamérica, como los ríos Amazonas y Orinoco.
La infección por este microoroganismo que habita en el suelo de cuevas y cavernas tropicales no se transmite de persona a persona y hasta ahora sólo ha sido detectada en pacientes extranjeros, sin que se haya reportado de forma natural en Chile.
Eduardo Álvarez, investigador del programa de microbiología y micología del ICBM explicó a Las Últimas Noticias, que este hongo "causa histoplasmosis, una infección pulmonar que suele presentarse como un resfrío que dura entre 10 a 15 días en pacientes normales, pero en el caso de pacientes que tengan una enfermedad de base asociada a su sistema inmunológico, por ejemplo leucemia o VIH, puede ser una enfermedad aguda y mortal".
El profesional precisó que este hongo "no se contagia directamente de persona a persona, eso está descartado al menos hasta ahora, por lo que aún teniendo en Chile a pacientes con este hongo, eso no representa un riesgo para la población".
Álvarez detalló al matutino que el contagio de este microorganismo ocurre "cuando la persona inhala sus esporas, que son estructuras esféricas microscópicas que ingresan al organismo vía nasal. Estas viajan a través del sistema respiratorio, llegan a los pulmones y en los alvéolos se transforman en levadura. En pacientes que tienen su sistema inmunológico comprometido, el hongo puede diseminarse al resto del cuerpo por la sangre".
De acuerdo con el investigador del ICBM, "los pacientes normales neutralizarán al hongo, y al cabo de 15 días lo eliminarán, pero en aquellos que tengan compromiso de su sistema inmunológico ocurre una evolución fulminante semejante a un shock séptico. En ese caso hay fibre, baja de la presión arterial, úlceras digestivas, endocarditis y meningitis, lo que en un par de semanas puede provocar la muerte".
Según lo informado por el rotativo, el tratamiento de esta enfermedad se realiza con antifúngicos similares a los antibióticos, pero que en vez de destruir bacterias destruyen hongos.